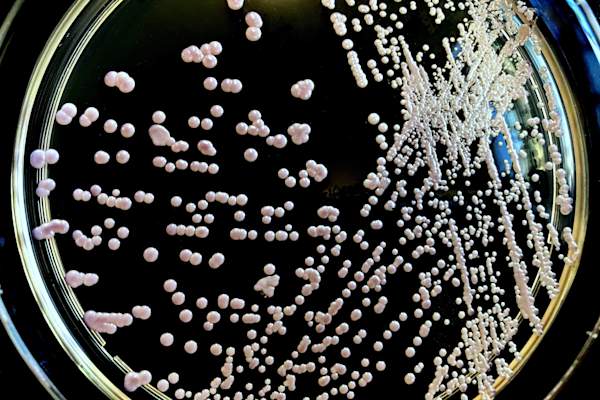

Coping With Vaginal Infections and Vaginal Atrophy After Menopause


So… You’re experiencing menopause. Now you have a high chance of developing vaginal atrophy (VA), a chronic condition that causes pain during sex and burning, itching, and other uncomfortable sensations in the vagina. It happens when women experience a decline in estrogen as they stop menstruating (or through other ways that estrogen runs out, like ovary removal or certain medications). And, it turns out, VA also increases your risk of developing urinary tract infections (UTIs) and vaginal infections like bacterial vaginosis (BV) and yeast infections. Fun, right? Here’s what you need to know about VA and these infections from two OB-GYNs.

How Does Menopause Increase Your Risk of Vaginal Infections?
在巴尔的摩的约翰霍金斯·贝景医疗中心的普通妇女局长,M.D.,杨柳·劳动学局长,M4D,杨氏议长,雌激素的雌激素水平往往会改变阴道的pH平衡。正常雌激素水平保持阴道酸性,但绝经妇女往往具有更大的基本环境。“某些细菌在更基本的条件下茁壮成长,所以有一些绝经后妇女可以更容易获得BV,”她说。由于更年期也增加了尿失禁的风险,Lawson博士在使用垫的女性中看到更多的酵母感染,这可以减少氧气流量。

Are Vaginal Infections More Common in Some Women?
If you have other chronic conditions in addition to VA, especially uncontrolled diabetes, you’re more likely to develop yeast infections, Dr. Lawson says, though this applies to women of any age, not just menopausal women. Another factor that can put you at increased risk for a yeast infection is taking antibiotics, like when you have a UTI, says Amy Park, M.D., section head of female pelvic medicine and reconstructive surgery at Cleveland Clinic in Cleveland, OH. “Sometimes people get into a cycle of getting recurrent UTIs, get them treated with antibiotics, and then they get yeast infections. I see that quite a bit,” she says.

您如何讲述感染和阴道萎缩之间的差异?
Dr. Lawson says sometimes the symptoms of both conditions can be similar—vaginal irritation or itching, discomfort with sitting, burning after urinating, or pain with intercourse. “It’s really hard to self-diagnose an infection unless you’re someone who gets them recurrently,” she says. Dr. Park notes that if you’re using over-the-counter treatments for a yeast infection and they’re not working, you should definitely check in with your doctor. And if you have a foul-smelling discharge, Dr. Lawson says this is not associated with VA and could be BV, so this also warrants a doctor’s visit.

How Can You Tell the Difference Between a UTI and a Vaginal Infection?
使用UTI,当你小便时,你可能会剧烈,燃烧疼痛,并且在劳森博士说,有些人在排尿后在他们的膀胱尿或痉挛中有血液。一个UTI可能会让你感觉如此糟糕,你会赶紧去看你的医生进行治疗,这是一件好事,因为感染可以蔓延到你的肾脏。对于阴道感染,Park博士说,通常你的阴道或外阴也是刺激的,也可能发痒。通过BV,您会注意到令人难以置疑的放电和酵母菌感染,它将是厚厚的白色,无味的放电。

如何治疗阴道感染与阴道萎缩?
Park博士,酵母感染如氟康唑如氟康唑(氟康唑)(如氟康唑)的抗真菌药(如氟康唑)的药丸治疗用甲硝唑处理细菌性阴道病,其可以口服或阴道凝胶;Clindamycin,阴道霜;或口服锡咪唑,通过处方提供。相比之下,VA通常用激素治疗治疗,以取代导致症状,润滑剂和保湿剂的减少的雌激素,以减少阴道干燥和/或扩张器扩大阴道。

如何降低与VA的阴道感染风险?
Park博士说,如果您患有糖尿病,请确保它受到控制,因为这使您在复发性Utis和酵母菌感染的风险较高。她还建议远离苛刻的肥皂和灌溉,因为你最终消除了好的和坏细菌。她说,穿着棉质裆部的内衣,如果你有尿失禁和va,请不要使用刺激性或带状垫。Lawson博士补充说,避免在淋浴或浴槽中避免将水引入阴道,因为这也可以让阴道中的细菌的平衡扰乱。
What Happens if I Keep Getting Vaginal Infections?
Park博士说,有抑制治疗如果您的感染保持返回,您的医生可以尝试。对于BV来说,她说初始治疗后,您的医生可能会在一周内每周使用甲硝唑凝胶一两次或两次。对于复发性酵母感染,您的医生可以在初始治疗后几个月每周氟康唑氏药。Lawson博士说,如果您有复发性酵母感染,则应要求进行一种叫做酵母的酵母Candida Glabrata.,这对常见的抗真菌治疗医生使用抵抗力。

Can Probiotics Help Prevent Vaginal Infections and Treat VA?
这一点,research似乎表明益生菌有助于平衡阴道环境,这可能有助于预防感染和treatva.。Dr. Lawson recommends that her patients eat plain Greek yogurt, drink kombucha, or take probiotic tablets at least three times a week. She notes also that using vaginal estrogen can help lessen your risk of BV and recurrent UTIs by balancing vaginal pH, so you may want to ask your doctor about options.

有风险离开阴道吗Infection Untreated?
“我认为大多数风险都与不适和瘙痒有关,”劳德森博士说。过度刮擦可能导致皮肤上的泪水,这也可能导致继发性皮肤感染,悲惨的经验,特别是在VA的顶部。“如果您有重大症状,则评估是重要的,”她说,加入即使简单的瘙痒可能是完全不同于感染的迹象,如早期的皮肤癌。Park博士说,如果您暴露于受感染的性伴侣,请将BV未经治疗的未经治疗可能会增加您获得性传播感染(STI)的风险。
- va.Definition and Prevalence:Cleveland Clinic. (2020). “Vaginal Atrophy: Overview.”my.clevelandclinic.org/health/diseases/15500-vaginal-atrophy
- VA和阴道感染:梅奥诊所。(2019)。“阴道萎缩:概述。”mayoclinic.org/diseases-conditions/vaginal-atrophy/symptoms-causes/syc-20352288
- Yeast Infection Treatments:梅奥诊所。(2019)。“酵母感染(阴道):诊断与治疗。”mayoclinic.org/diseases-conditions/yeast-infection/diagnosis-treatment/drc-20379004
- BV Treatments:梅奥诊所。(2019)。“Bacterial vaginosis: Diagnosis & treatment.”mayoclinic.org/diseases-conditions/bacterial-vaginosis/diagnosis-treatment/drc-20352285
- Probiotics and Vaginal Infections:Journal of Menopausal Medicine。(2017)。“益生菌在绝经后阴道感染的预防和治疗:审查文章”。ncbi.nlm.nih.gov/pmc/articles/PMC5770522/
- 益生菌和va:Menopause。(2014)。“阴道微生物群,更年期状态和外阴萎缩萎缩的迹象之间的关联。”ncbi.nlm.nih.gov/pmc/articles/PMC3994184/